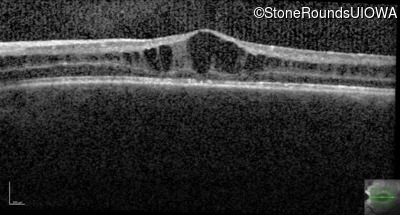
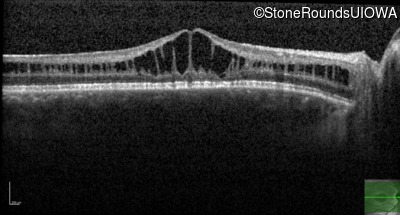
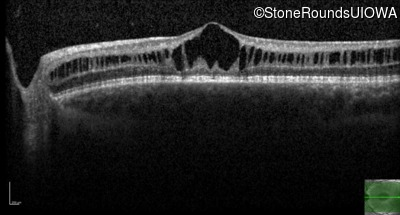
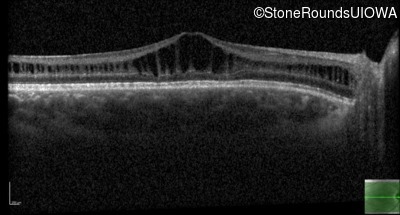
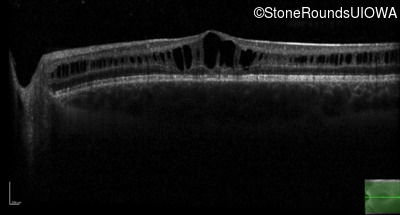
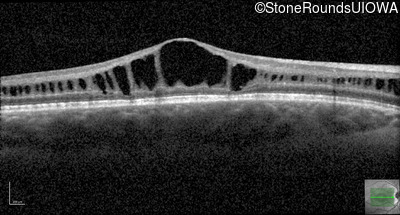
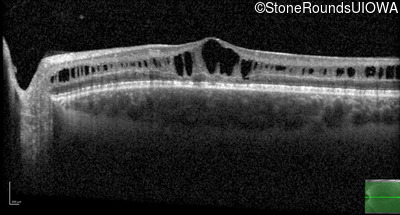
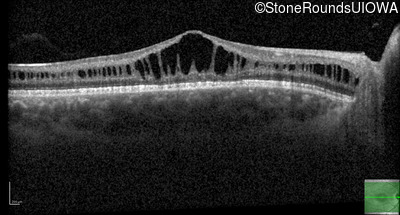
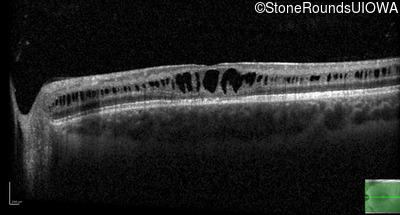

Case
SR482
Student Mode
XL Retinoschisis (IIIB1)
Male
Male
Hidden
SR482
Student Mode
XL Retinoschisis (IIIB1)
Male
Male
History
This 11 year old male was never correctable to 20/20. He received glasses at age 1 for esotropia. His refraction is +4.25 +2.00 x 105 OD and +2.00 +2.00 x 80 OS.
| Age at visit: 11 years |
| Age at visit: 13 years |
| Age at visit: 15 years |
| Age at visit: 17 years |
Diagnosis & molecular findings
| Disease | Gene | Allele 1 variant(s) | Allele 2 variant(s) | Inheritance mode |
|---|---|---|---|---|
| XL Retinoschisis | RS1 | Trp96Arg TGG>CGG | XL |